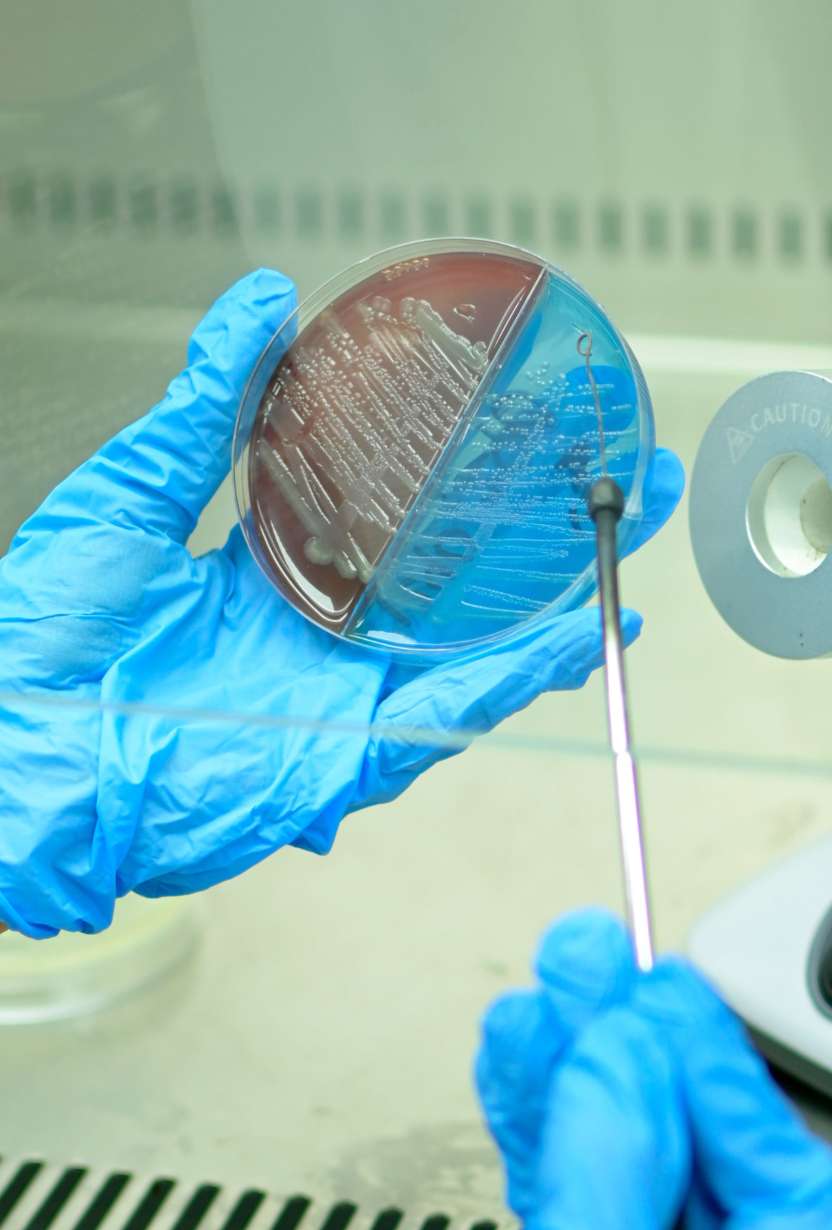
Laboratorio

Disponibilidad
24 horas, 7 días a la semana
Laboratorio
Equipos automatizados de última generación con envío de resultados vía digital.
Diagnóstico y Atención Médica
Última Generación
24/7 Disponible
✓ Disponible: Servicio disponible las 24 horas del día, los 365 días del año.
Descripción del Servicio
Nuestro laboratorio cuenta con equipos automatizados de análisis de última generación que garantizan el control y calidad en los resultados. Contamos con profesionales altamente capacitados e instalaciones modernas con alta tecnología. Somos el único laboratorio en la región en procesar gases arteriales y venosos con entrega inmediata. Procesamos perfiles de química, hematología, orinas y heces, pruebas especiales, bacteriología, inmunoglobulinas, marcadores tumorales, serología, hepatitis, coprología y uroanálisis.
Nuestro Compromiso
Ofrecer atención médica de la más alta calidad con tecnología de vanguardia y personal altamente capacitado, garantizando diagnósticos precisos y tratamientos efectivos para nuestros pacientes.